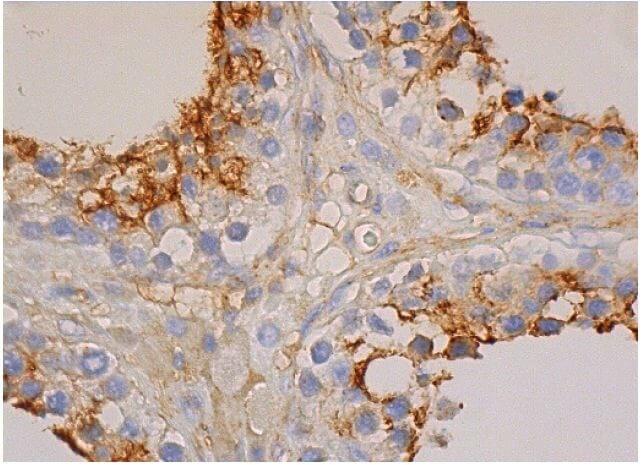
cd0881

product description:

CD081

CD081
Anti-Semitic Acts in U.K. Spike in First Half of 2016 cd0881 Germany to Finally Overturn 50,000 Convictions for Male Homosexuality cd0881 Turkey Releases Hundreds of Soldiers Detained After Coup Attempt cd0881 ISIS Defector From New York: 'I've Let My Nation Down' cd0881
cd0881 Gold White Black Red Blue Beige Grey Price Rose Orange Purple Green Yellow Cyan Bordeaux pink Indigo Brown Silver
Product reviews:



Harley
2025-12-22 iphone 6s Plus
CD81 Antibody - Cat. No. 5195 | ProSci cd0881
cd0881

Tyrone
2025-12-12 iphone 7
Changes in Soluble Serum CD81 Concentration during an Oral Glucose Tolerance Test in Patients cd0881
cd0881

Hiram
2025-12-21 iphone 7 Plus
CD81 Antibody (5A6) | SCBT - Santa Cruz Biotechnology cd0881
cd0881

Customer Reviews:
| Full Name: | |
| Title: | |
| Description: | |
| Rating Value: | |
| Time: | 2025-12-23 00:46:03 |
Customers who viewed this item also viewed: